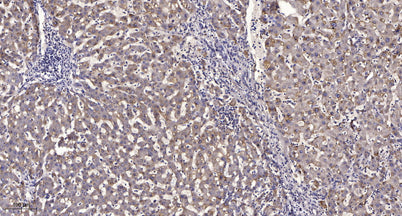
CES2 rabbit pAb

Product Overview
Product Overview
Applications
WB;IHC;IF;ELISA
Cellular localization
Endoplasmic reticulum lumen .
Clonality
Polyclonal
Concentration
1 mg/ml
Cost per item
74
Geneid human
8824
Human swiss prot no
O00748
Immunogen
Synthesized peptide derived from the Internal region of human CES2.
Isotype
IgG
Observed band
61kD
Product weight
0.005kg
Reactivity
Human;Rat;Mouse;
Recommended dilutions
Western Blot: 1/500 - 1/2000. Immunohistochemistry: 1/100 - 1/300. ELISA: 1/40000. Not yet tested in other applications.
Source
Rabbit
Storage
-20°C/1 year
Documents
Documents
Documents
Backgrond
Backgrond
This gene encodes a member of the carboxylesterase large family. The family members are responsible for the hydrolysis or transesterification of various xenobiotics, such as cocaine and heroin, and endogenous substrates with ester, thioester, or amide bonds. They may participate in fatty acyl and cholesterol ester metabolism, and may play a role in the blood-brain barrier system. The protein encoded by this gene is the major intestinal enzyme and functions in intestine drug clearance. Alternatively spliced transcript variants have been found for this gene.[provided by RefSeq, Oct 2010],
Product Citations
Product Citations
More Info
More Info
CES2 rabbit pAb
CES2 rabbit pAb
Vendor: ELK Biotechnology
SKU: ES7883
Regular price
$148.00
Sale price
$148.00
Regular price
Unit price
/per
Shipping calculated at checkout.
Documents
Available in stock (100)
×
Request a Quote
- Free Shipping over $2500
- AI AgentFor Any Questions or Product Search Help
- Track Your Order Status Anytime
Couldn't load pickup availability
Limited time offer
Get $200 off when you spend $2,500 or more!
Product Overview
Product Overview
Applications
WB;IHC;IF;ELISA
Cellular localization
Endoplasmic reticulum lumen .
Clonality
Polyclonal
Concentration
1 mg/ml
Cost per item
74
Geneid human
8824
Human swiss prot no
O00748
Immunogen
Synthesized peptide derived from the Internal region of human CES2.
Isotype
IgG
Observed band
61kD
Product weight
0.005kg
Reactivity
Human;Rat;Mouse;
Recommended dilutions
Western Blot: 1/500 - 1/2000. Immunohistochemistry: 1/100 - 1/300. ELISA: 1/40000. Not yet tested in other applications.
Source
Rabbit
Storage
-20°C/1 year
Documents
Documents
Documents
Backgrond
Backgrond
This gene encodes a member of the carboxylesterase large family. The family members are responsible for the hydrolysis or transesterification of various xenobiotics, such as cocaine and heroin, and endogenous substrates with ester, thioester, or amide bonds. They may participate in fatty acyl and cholesterol ester metabolism, and may play a role in the blood-brain barrier system. The protein encoded by this gene is the major intestinal enzyme and functions in intestine drug clearance. Alternatively spliced transcript variants have been found for this gene.[provided by RefSeq, Oct 2010],
Product Citations
Product Citations
More Info
More Info

CES2 rabbit pAb
Regular price
$148.00
Sale price
$148.00
Regular price
Unit price
/per